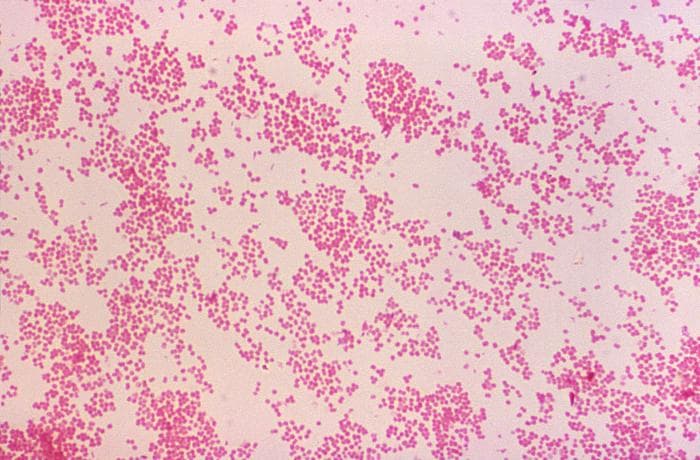

Las bacterias son microorganismos procariotas que se encuentran en todos los hábitat de la Tierra, incluso en los más extremos. Se encuentran en el suelo, agua, plantas, organismos biológicos, desechos y en la corteza terrestre.
10 impresionantes fotografías de bacterias al microscopio
En general tienen alrededor de unos micrómetros de largo y pueden tener distintas formas, como esferas, espirales o barras. En el mundo, los científicos estiman que hay cerca de 1 nonillón (es decir un 1 con 30 ceros a continuación), de las cuales solo se han estudiado una mínima cantidad.
En la bacteriología se estudian a las bacterias, comenzando por su aspecto macroscópico y microscópico. La caracterización macroscópica de las bacterias suele realizarse mediante la observación visual de su crecimiento en un medio de cultivo en placas de agar. En esta ocasión, se observa principalmente el tamaño, la forma, el color, la forma, entre otras características visuales.
Al microscopio, se utiliza una técnica de tinción para revelar la forma, agrupación y estructura de las células bacterianas. En general, este es el paso principal para identificar una bacteria. A continuación, verás 10 fotografías de bacterias al microscopio.
- Ver también: «Clasificación de las bacterias según su forma»
10. Aeromonas

9. Staphylococcus

8. Enterococcus

7. Listeria

6. Lactobacillus
lactobacillus.png
5. Streptomyces

4. Clostridium

3. Neisseria

2. Bordetella

1. Corynebacterium
800px-corynebacterium_diphtheriae_gram_stain.jpg
¿Qué te parecieron estas imágenes? ¿Te las imaginabas así?
Quizá también te pueda interesar: